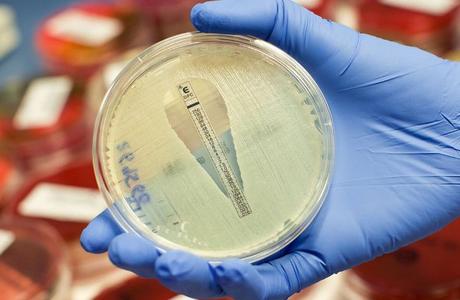
Uso incorrecto de antibióticos por diagnósticos erróneos

Los diagnósticos erróneos pueden conducir a un aumento del riesgo del uso incorrecto de antibióticos, amenazando los resultados de los pacientes y la eficacia antimicrobiana, a la vez que aumenta los costos sanitarios.
Todo uso de antibióticos establece una presión selectiva que contribuye a la aparición incesante de resistencia en una amplia gama de patógenos y se han introducido programas de administración de antimicrobianos para mejorar la terapia antimicrobiana, pero en la mayoría de los casos las mejoras son modestas.
Especialistas en enfermedades infecciosas en el Sistema de Salud de Asuntos de Veteranos de Minneapolis, (Minnesota, MN, EUA) y sus colegas universitarios, realizaron un estudio de cohorte retrospectivo en su Centro Médico (MVAMC), evaluando 500 casos de pacientes hospitalizados para examinar los diagnósticos de proveedores, categorizados como correctos, indeterminados, incorrecto, o un signo o síntoma consistente con una enfermedad infecciosa en lugar de un síndrome o enfermedad específica, y con el fin de determinar si el curso antimicrobiano formulado era apropiado.
Los científicos encontraron que el 95% de los pacientes con un diagnóstico incorrecto o indeterminado, o con un síntoma identificado, pero sin diagnóstico, fueron formulados con antibióticos inapropiados. En comparación, sólo el 38% de los pacientes que recibieron un diagnóstico correcto fueron formulados antibióticos de forma incorrecta. El uso inapropiado de antibióticos contribuye a la resistencia a los antibióticos, el fracaso clínico, eventos adversos a los medicamentos y costos excesivos. Adicionalmente, encontraron que, en general, sólo el 58% de los pacientes recibió un diagnóstico correcto, lo que indica que los errores de diagnóstico fueron más prevalentes en su estudio que en los estudios anteriores no relacionados con el uso de sustancias antimicrobianas. Los diagnósticos erróneos más comunes identificados por los especialistas fueron neumonía, cistitis, infecciones del tracto urinario, infecciones renales y urosepsis.
Los autores concluyeron sobre el impacto de la exactitud del diagnóstico de la enfermedad sobre la idoneidad de la terapia antimicrobiana y proporcionaron un análisis detallado de los tipos y los predictores de errores de diagnóstico y su relación con los tipos de uso inadecuado de los antimicrobianos. Estos hallazgos sugieren que se necesitan más estudios para dilucidar los mecanismos de los errores diagnósticos relacionados con la formulación de los antibióticos. También sugieren que los programas de administración de antimicrobianos podrían aumentar su impacto si fueron diseñados para ayudar a los proveedores a hacen diagnósticos iniciales exactos y para ayudar a los proveedores a saber cuándo la terapia antimicrobiana puede ser retenida de manera segura.
Gregory A. Filice, MD, autor principal del estudio, dijo: "La exactitud diagnóstica es esencial para el uso seguro de los antibióticos. Con el fin de mejorar el uso de antibióticos en la atención sanitaria, debemos tener en cuenta este desafío y buscar herramientas y estrategias que ayuden a los médicos a reducir el uso innecesario y potencialmente dañino de los antibióticos". El estudio fue publicado el 18 de mayo de 2015, en la revista Infection Control & Hospital Epidemiology.
